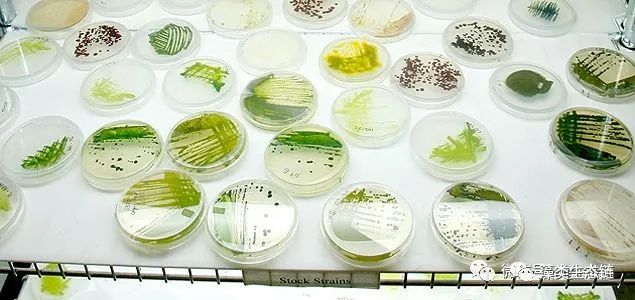
藻类植物介绍与藻类光生物反应器设计(图8)
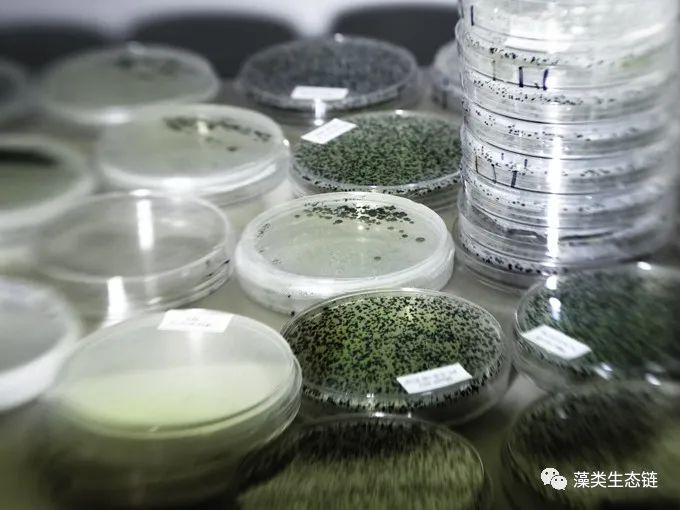
藻类植物介绍与藻类光生物反应器设计(图9)
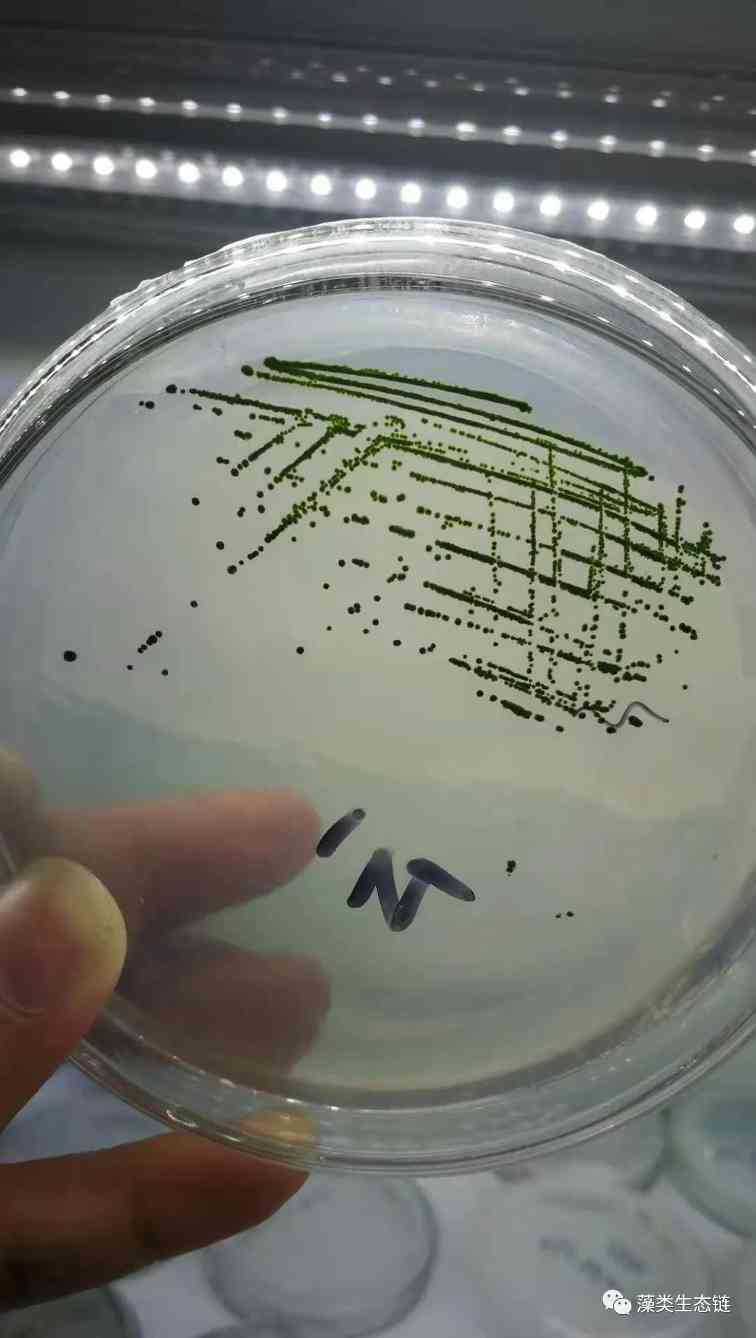
藻类植物介绍与藻类光生物反应器设计(图10)
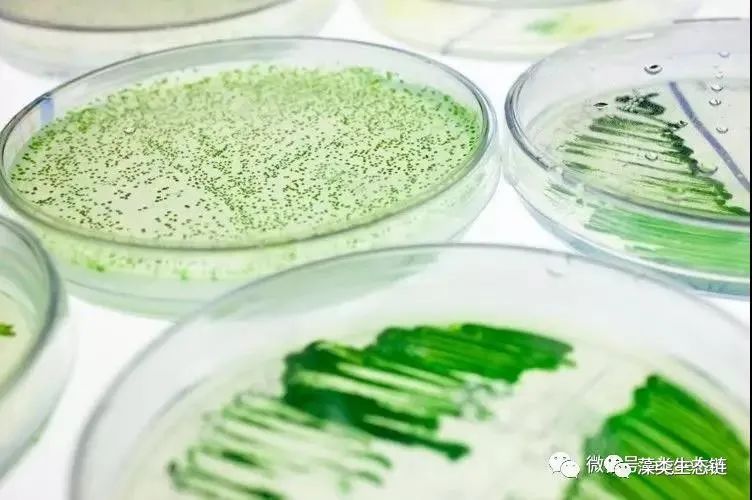
藻类植物介绍与藻类光生物反应器设计(图12)

我们看到的从很远星系来的光是在几百万年之前发出的,在我们看到的最远的物体的情况下,光是在80亿年前发出的。这样当我们看宇宙时,我们是在看它的过去。
——霍金《时间简史》


(1)藻类植物介绍 Algae(alga)
一、藻类植物概述
(一) 藻类植物的特征
1. 具有光合作用色素
2. 生殖器官多为单细胞,无保护层保护
3. 无根、茎、叶的分化
4. 无胚的形成
(二) 藻类植物的分类
1. 根据光合色素的种类
2. 贮藏养分的种类
3. 细胞壁的成分
4. 鞭毛有无及着生的位置和类型
5. 有性生殖的方式:同配生殖;异配生殖;卵式生殖
6. 生活史
7. 根据上述特征,把藻类分成9门:蓝藻门、裸藻门、甲藻门、金藻门、黄藻门、硅藻门、绿藻门、红藻门、褐藻门
此外:藻类的分门分纲,不同的学者有不同的观点。
隐藻门(甲藻门 隐藻纲Cryptophyceae 隐鞭藻目)
轮藻门(绿藻门 轮藻纲Characeae 轮藻目Charales 轮藻属Chara——复杂原植体)
原绿藻门
植物体具叶绿素,?
1. 仅有叶绿素a(叶绿素c在某些黄藻门的种中存在)?
2. 原核生物——蓝藻门Cyanophyta
2.真核生物?
3.具有水溶性的蓝色素和红色素——红藻门Rhodophyta?
3.具有质体色素叶黄素(叶绿素c存在于某些种)——黄藻门Xanthophyta?
1.具有叶绿素a和c?
4.具有纤维素细胞壁的大型海藻——褐藻门Phaeophyta?
4.具有纤维素细胞壁的小型、多为单细胞的藻类,前端具有2条不等鞭毛——
金藻门Chrysophyta
4.具有硅质的细胞壁的小型、多为单细胞的藻类——硅藻门Bacillariphyta
4.缺乏细胞壁或有纤维素板的细胞壁;具侧生的2条不等鞭毛——
甲藻门Pyrrohophyta
1.具叶绿素a和b?
5.缺乏细胞壁的单细胞藻类——裸藻门Euglenophyta
5.有细胞壁,有复杂分化的藻类——绿藻门Chlorophyta


分 类
藻类在植物界属于低等植物。藻类学家一般将藻类共分11个门,其顺序如下:
1.蓝藻门Cyanophyta 下设1纲,蓝藻纲Cyanophyceae。
2.金藻门Chrysophyta 常设1纲,金藻纲Chrysophyceae。
3.黄藻门Xanthophyta 分为2个纲,黄藻纲Xanthophyceae和绿胞藻纲Chloromonadaphyceae。
4.硅藻门Bacillariophyta 根据壳的形状和花纹排列方式,硅藻门分成2个纲。中心硅藻纲Centriae和羽纹硅藻纲Pennatae。
5.甲藻门Pyrrophyta 仅1纲,甲藻纲Pyrrophyceae。
6.隐藻门Cryptophyta 仅1纲,隐藻纲Cryptophyceae。
7.裸藻门Euglenophyta 仅1纲,裸藻纲Euglenopbyceae。
8.绿藻门Chlorophyta 分为2个纲,即绿藻纲Chlorophyceae和接合藻纲Conjugatophyceae。
9.轮藻门Charophyta 1目,轮藻目:丽藻属、轮藻属
10.褐藻门Fhaeophyta ——海带
11.红藻门Rhodophyta ——紫菜属
浮游藻类一般多见于前八个门,轮藻、褐藻和红藻门主要是大型藻类。
一般将原生动物分为5纲:鞭毛纲(Mastigophora)、肉足纲(Sarcodina)、纤毛纲(Ciliatea)、孢子纲(Sporozoa)和吸管虫纲(Suctoria)。
轮虫隶属轮形动物门Phylum Rotifera,轮虫纲Rotifera。
枝角类隶属于节肢动物门(Arthropoda),甲壳动物纲(Crustacea),鳃足亚纲。
桡足类隶属于节肢动物门,甲壳纲,桡足亚纲。
(2)藻类培养和繁殖
一、藻种提纯的思路方法
(1)分离筛选藻种的一般步骤是:样品准备→富集培养→纯种分离(筛选)→纯种保存
二、藻种分离纯化介绍(固体培养基分离和纯化)
(1)方法1: 涂布平板法首先把微生物悬液作一系列的稀释(如1:10、1:100、1:1000、1:10000),然后分别取不同稀释液0.1毫升加到琼脂平板涂布。
(2)方法2:平板划线法 ?最简单的分离藻种的方法是平板划线法,即用接种环以无菌操作沾取少许待分离的材料,在无菌平板表面进行连续划线,藻细胞数量将随着划线次数的增加而减少,并逐步分散开来,如果划线适宜的话,藻细胞能一一分散,经培养后,可在平板表面得到单藻落。有时这种单藻落并非都由单个细胞繁殖而来的,故必须反复分离多次才可得到纯种。
样品准备
镜检:细胞大小均匀、饱满度高、色素体均匀,无原生动物、杂藻,细菌少。 ?处理方法:
1.控制液体总菌量<103cfu/ml(使用离心机处理)。
2.没有离心机的可采用藻液:培养液(添加抗生素)=1:10稀释后再划培养皿。
富集培养
1.取1毫升样品接种至含4毫升营养液的试管中培养(接种培养液占试管体积不超过1/3)。
2.培养时间:3-5天。
倒培养基
1、温度:50-60℃左右,添加营养盐。
2、左手拿培养皿,以中指、无名指和小指托住皿底,拇指和食指夹住皿盖,靠近火焰,将皿盖掀开,角度尽量小于45°。
3、边缘不能有琼脂。
4、体积:1/3-2/3
5、放置24h(培养皿表面不能有水珠等)

培养皿划线(分离、保种)
注意事项:
1.平板表面不可
以有水膜或水滴。
2.挑取藻落时,
动作要轻,挑取量
不能过多。
–菌落多时: –菌落少时:

轻:不留痕迹
3.接种环的环要圆滑,环平面与培养基表面之间的夹角要小于45°,划线时以腕力在培养基表面作轻快的滑动,勿使平板表面划破嵌进培养基,线条间平行而且紧密,但是不要重叠。
4.挑取藻落要适中,不要太多也不要太少。藻落量一般为直径1mm。

培养皿培养
1.光照:3000-5000lux
2.温度:26-28℃
3.培养时间:3-5天

藻种筛选
筛选指标:
1.藻色:浓、亮、活
2.菌:菌落少
3.镜检:无原生动物、变异少
纯种保种
1.纯种保存1
低温:10-12℃
光照:小于1000lux
时长:8-12h/d
保存时间:1个月
光照培养箱
2.纯种保存2
低温:4-5℃
光照:小于500lux
时长:1-2h/d
保存时间:3个月
冰箱

纯种培养
一、平板镜检→试管培养(接种环挑取一个单藻落接种至5毫升培养液试管中)
二、5ml藻种→接种至50ml培养(按10%接种量接种)
三、. 50ml藻种→接种至200ml培养(按25%接种量接种)
四、 200ml藻种→接种至400ml培养(按50%接种量接种)
五、400ml藻种→接种至800ml培养(按50%接种量接种)
六、2000ml藻种→接种至4000ml培养(按50%接种)
图片展示(涂布与划线)
培养基配方



消毒与灭菌方法包括
1.物理方法(紫外、高压蒸汽、干热灭菌);
2.化学方法(环氧乙烷、次氯酸钠、70-75%乙醇);
3.生物方法(青霉素-、氯霉素+和红霉素-+);
灭菌在器具灭菌和培养基配制中的运用

